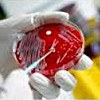

Другие названия и синонимы
Laboratory tests in gynecology.
Описание
Лабораторные тесты в гинекологии являются наиболее поучительными методами, которые позволяют надежно диагностировать и оценивать эффективность лечения. Лабораторная диагностика в гинекологии обычно проводится несколько раз: для определения патологии, для оценки динамики лечения и контроля лечения. Генитальные мазки, аспирация матки, соскоб Они имеют наибольшее диагностическое значение; биологические материалы. Мазки исследуют с помощью микроскопии, бактериологического культивирования питательных сред, ELISA и ПЦР, а также цитологического анализа. Для получения достоверных результатов важен правильный мазок.
Лабораторные исследования в области гинекологии являются наиболее информативными методами, позволяющими установить достоверную диагностику и оценить эффективность лечения. Лабораторная диагностика в гинекологии обычно проводится несколько раз: для определения патологии, для оценки динамики лечения и контроля излечения. Мазки половых путей, аспирация матки, соскобы Имеют наибольшее диагностическое значение; биологические материалы.
Лабораторные исследования в области гинекологии являются наиболее информативными методами, позволяющими установить достоверную диагностику и оценить эффективность лечения. Лабораторная диагностика в гинекологии обычно проводится несколько раз: для определения патологии, для оценки динамики лечения и контроля излечения. Мазки половых путей, аспирация матки, соскобы Имеют наибольшее диагностическое значение; биологические материалы.
|
|
Дополнительные факты
Правильная подготовка пациента к сбору биологического материала для исследования повышает достоверность результатов анализа и точность клинического диагноза. Накануне взятия гинекологических мазков не следует использовать влагалищные дезинфицирующие средства и антибактериальные средства, душевые, использовать вагинальные суппозитории и вступать в половые контакты менее чем за 36 часов до взятия мазка. Также рекомендуется прекратить прием антибактериальных или уросептических средств за 2 недели до исследования или возобновить анализ позже. Гинекологические мазки не принимаются во время менструации. За 2 часа до взятия мазка женщина не должна мочиться. Материал для взятия проб должен быть взят перед обследованием двумя руками и кольпоскопией.
Отдельные стерильные инструменты берут мазки из мочеиспускательного канала, шейки матки и задней влагалищной свода и помещают их отдельно на предметные стекла, отмечая прием мазков: «U» - уретра, «C» - шейка матки, «V» - влагалище. Чашки сушат на воздухе и отправляют в лабораторию в направлении, где пятна окрашиваются и подвергаются микроскопическому исследованию.
В этом случае биологический материал высевается при определенной температуре на питательные среды, что приводит к размножению микроорганизмов и идентификации инфекционного агента. Бактериологический посев является наиболее значимым с точки зрения бактерий и грибков, но с точки зрения вирусов и других инфекций он часто сочетается с методом ПЦР. Результат анализа готов через неделю. Результаты бактериологического сева позволяют проводить рациональную антибактериальную терапию.
Тот же метод используется для сбора материала для резервуара. посев кандидоза с использованием определенной питательной среды. Мазок выводится из влагалища. При наличии грибков кандида в мазке они начинают размножаться и образовывать колонии. Посев на кандидоз позволяет обнаружить наличие или отсутствие гриба, его вида, провести количественный расчет грибов-кандидоз, культивируемых при посадке, а также определить его чувствительность к противогрибковой активности. Для точности анализа необходимо вырастить количество грибов кандида (10000 КОЕ / мл).
Бактериологическая инокуляция урогенитальных микоплазм (микоплазм, уреаплазм) с определением чувствительности представляет собой метод разведения возбудителей микоплазмоза и уреаплазмоза на носителе. У женщин мазки взяты из влагалищных дуг, из шейки матки, из слизистой оболочки мочеиспускательного канала. После получения результата определяется отсутствие или наличие увеличения того или иного возбудителя, оцениваются количественные показатели теста и чувствительность к антибиотикам. Бактериологические растения являются «золотыми стандартами» в диагностике генитальных инфекций, но имеют ряд недостатков: продолжительность исследования и достоверность результата только тогда, когда в биологическом материале присутствуют биологические патогены.
Мазки, полученные из разных частей репродуктивной системы, наносят на предварительно обезжиренное и маркированное стекло, фиксируют специальным составом, окрашивают и исследуют под микроскопом. При обнаружении подозрительных клеток проводится кольпоскопия с биопсией или диагностическим выскабливанием с последующим гистологическим исследованием материала. Метод цитологического исследования очень информативен в диагностике рака женских половых органов. Цитологический мазок - обязательное ежегодное обследование для женщин, имеющих половые контакты.
Микроскопия мазка.
Наиболее частым исследованием в гинекологической практике является микроскопия (бактериоскопия) мазка - исследование секрета нижних мочевых путей (влагалища, цервикального канала и уретры) под микроскопом. Этот анализ проводится практически при каждой консультации гинеколога и известен как пятно на флоре и степень чистоты влагалища. Микроскопия мазка оценивает количество и пропорцию клеточных элементов, а также микроорганизмов микрофлоры, условно-патогенных и патогенных, что указывает на наличие или отсутствие определенных патологических процессов.Отдельные стерильные инструменты берут мазки из мочеиспускательного канала, шейки матки и задней влагалищной свода и помещают их отдельно на предметные стекла, отмечая прием мазков: «U» - уретра, «C» - шейка матки, «V» - влагалище. Чашки сушат на воздухе и отправляют в лабораторию в направлении, где пятна окрашиваются и подвергаются микроскопическому исследованию.
Бактериологические посевы.
Когда бактериологическая культура покрыта антибиотиком (культура на микрофлоре), определяется тип возбудителя, количественно подсчитываются микробы и определяются антибактериальные агенты, против которых эти микроорганизмы наиболее чувствительны. Материал для бактериологического исследования взят стерильным тампоном на проволоке, который сразу же помещают в пробирку и отправляют в лабораторию. Основное условие надежности танка. При посеве необходимо соблюдать стерильность, чтобы в материал не попали бактерии из воздуха, кожи.В этом случае биологический материал высевается при определенной температуре на питательные среды, что приводит к размножению микроорганизмов и идентификации инфекционного агента. Бактериологический посев является наиболее значимым с точки зрения бактерий и грибков, но с точки зрения вирусов и других инфекций он часто сочетается с методом ПЦР. Результат анализа готов через неделю. Результаты бактериологического сева позволяют проводить рациональную антибактериальную терапию.
Тот же метод используется для сбора материала для резервуара. посев кандидоза с использованием определенной питательной среды. Мазок выводится из влагалища. При наличии грибков кандида в мазке они начинают размножаться и образовывать колонии. Посев на кандидоз позволяет обнаружить наличие или отсутствие гриба, его вида, провести количественный расчет грибов-кандидоз, культивируемых при посадке, а также определить его чувствительность к противогрибковой активности. Для точности анализа необходимо вырастить количество грибов кандида (10000 КОЕ / мл).
Бактериологическая инокуляция урогенитальных микоплазм (микоплазм, уреаплазм) с определением чувствительности представляет собой метод разведения возбудителей микоплазмоза и уреаплазмоза на носителе. У женщин мазки взяты из влагалищных дуг, из шейки матки, из слизистой оболочки мочеиспускательного канала. После получения результата определяется отсутствие или наличие увеличения того или иного возбудителя, оцениваются количественные показатели теста и чувствительность к антибиотикам. Бактериологические растения являются «золотыми стандартами» в диагностике генитальных инфекций, но имеют ряд недостатков: продолжительность исследования и достоверность результата только тогда, когда в биологическом материале присутствуют биологические патогены.
Цитологические исследования.
В гинекологии соскоб шейки матки, аспираты матки, оттиски внутриматочного устройства могут пройти цитологическое исследование для выявления злокачественных опухолей в гинекологии. Цитологическое исследование исследует клеточный состав мазка и наличие атипичных клеточных комплексов. Цитологическое исследование мазков шейки матки берется из влагалищной части и канала шейки матки с помощью ложки Фолькмана, специального шпателя или бороздчатого зонда. Аспират из матки получают с помощью катетера, прикрепленного к коричневому шприцу со свободным концом.Мазки, полученные из разных частей репродуктивной системы, наносят на предварительно обезжиренное и маркированное стекло, фиксируют специальным составом, окрашивают и исследуют под микроскопом. При обнаружении подозрительных клеток проводится кольпоскопия с биопсией или диагностическим выскабливанием с последующим гистологическим исследованием материала. Метод цитологического исследования очень информативен в диагностике рака женских половых органов. Цитологический мазок - обязательное ежегодное обследование для женщин, имеющих половые контакты.

Диагностика
Метод ДНК-диагностики генитальных инфекций основан на обнаружении ДНК того или иного возбудителя в биологическом материале. Методы диагностики ДНК включают ПЦР (полимеразная цепная реакция) соскобов из уретры, шейки матки и влагалища. С помощью исследований ПЦР вирусы, бактерии, простейшие, грибки Они также выявляются в едином количестве, что позволяет диагностировать медленные и латентные инфекции (уреаплазмоз, хламидиоз, микоплазмоз, ВПЧ, генитальный герпес и ).
Материал забирается специальной стерильной одноразовой кисточкой. Перед взятием мазка слизь и выделения удаляются ватным тампоном. Так как большинство патогенов, обнаруженных методом ПЦР, являются внутриклеточными паразитами, необходимо очистить эпителиальные клетки для обнаружения, а не для выведения. Собранный материал помещается в контейнер с физиологическим раствором, который хранится в холодильнике перед доставкой в лабораторию.
ПЦР - это высокочувствительный и специфический метод диагностики, который зависит от совместимости стерильности, принципов отбора проб и технологии лабораторных исследований. Методом ПЦР-диагностики выявляется вирус папилломы человека (ВПЧ), который во многих случаях вызывает дисплазию, рак шейки матки и генитальные бородавки. Высоко канцерогенные типы ВПЧ включают 16, 18, 31, 33, 35, 39, 45, 52, 56, 58, 59, 66, что увеличивает вероятность развития рака шейки матки до 40%.
Материалом для определения высокого риска ВПЧ является соскоб шейного эпителия (шейного отдела), шейки матки (цервикальный канал) или зоны трансформации (дисплазия). Материал собирается в одноразовые контейнеры (тубы, контейнеры) с использованием специальных транспортных средств. После удаления слизи из области шейки матки с помощью стерильного ватного тампона в шейный канал вводится цитощетка, которая совершает два полных поворота влево и вправо. Осторожно, избегая прикосновения к стенкам влагалища, кисть снимается и помещается в емкость с транспортирующим средством. Собранный материал можно хранить в течение 48 часов при + 2 + 8 ° С.
Другие виды лабораторных исследований в гинекологии могут быть назначены врачом на основании клинических симптомов заболевания. Лабораторные тесты в гинекологии широко используются в диагностике, назначении лечения и мониторинге состояния пациента.
Материал забирается специальной стерильной одноразовой кисточкой. Перед взятием мазка слизь и выделения удаляются ватным тампоном. Так как большинство патогенов, обнаруженных методом ПЦР, являются внутриклеточными паразитами, необходимо очистить эпителиальные клетки для обнаружения, а не для выведения. Собранный материал помещается в контейнер с физиологическим раствором, который хранится в холодильнике перед доставкой в лабораторию.
ПЦР - это высокочувствительный и специфический метод диагностики, который зависит от совместимости стерильности, принципов отбора проб и технологии лабораторных исследований. Методом ПЦР-диагностики выявляется вирус папилломы человека (ВПЧ), который во многих случаях вызывает дисплазию, рак шейки матки и генитальные бородавки. Высоко канцерогенные типы ВПЧ включают 16, 18, 31, 33, 35, 39, 45, 52, 56, 58, 59, 66, что увеличивает вероятность развития рака шейки матки до 40%.
Материалом для определения высокого риска ВПЧ является соскоб шейного эпителия (шейного отдела), шейки матки (цервикальный канал) или зоны трансформации (дисплазия). Материал собирается в одноразовые контейнеры (тубы, контейнеры) с использованием специальных транспортных средств. После удаления слизи из области шейки матки с помощью стерильного ватного тампона в шейный канал вводится цитощетка, которая совершает два полных поворота влево и вправо. Осторожно, избегая прикосновения к стенкам влагалища, кисть снимается и помещается в емкость с транспортирующим средством. Собранный материал можно хранить в течение 48 часов при + 2 + 8 ° С.
Другие виды лабораторных исследований в гинекологии могут быть назначены врачом на основании клинических симптомов заболевания. Лабораторные тесты в гинекологии широко используются в диагностике, назначении лечения и мониторинге состояния пациента.